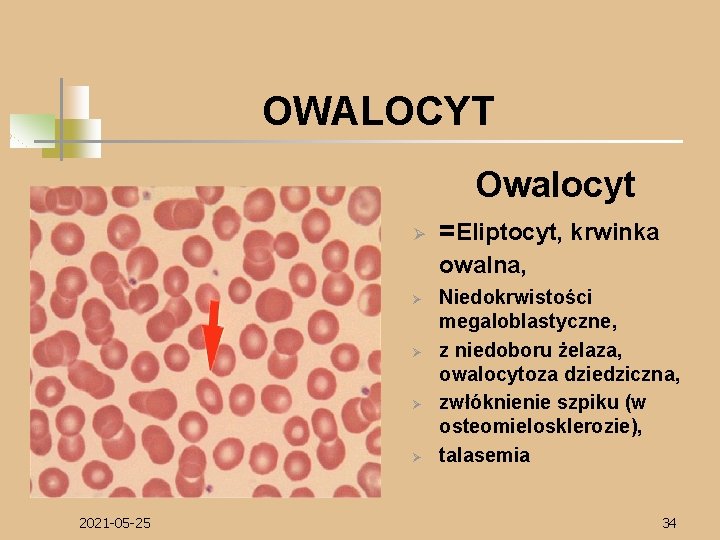
OWALOCYT Owalocyt Ø =Eliptocyt, krwinka owalna, Ø Ø 2021 -05 -25 Niedokrwistości megaloblastyczne, z

INTERPRETACJA BADA MORFOLOGII KRWI Katedra i Klinika Hematologii

INTERPRETACJA BADAŃ MORFOLOGII KRWI Katedra i Klinika Hematologii, Onkologii i Chorób Wewnętrznych AM w Warszawie 2021 -05 -25 1

KREW 1. jest tkanką płynną złożoną z osocza (55%) i elementów morfotycznych (komórkowych) (45%) osocze składa się z wody, w której rozpuszczone są wielkocząsteczkowe białka , substancje lipidowe oraz jony, witaminy i sole mineralne elementy komórkowe: erytrocyty, leukocyty, trombocyty 3. 2021 -05 -25 dorosły człowiek posiada 3, 8 - 5, 4 l krwi 2. 2

Wskaźniki: układ białokrwinkowy WBC leukocyty LY, LYMP, LYMPH NE, NEUT, GRAN Mo, MONO Eo, Eos Ba, BASO limfocyty neutrocyty monocyty eozynocyty bazocyty MXD, MID średnie i duże krwinki białe : eozynocyty, bazocyty, monocyty, blasty, itd. LUC duże komórki nie zawierające peroksydazy: erytroblasty, pobudzone limfocyty, plazmocyty, limfoblasty, mieloblasty peroksydazoujemne 2021 -05 -25 3

Wskaźniki: układ czerwonokrwinkowy RBC liczba krwinek czerwonych HCT (Ht, PCV) hematokryt HGB stężenie hemoglobiny we krwi MCV średnia objętość krwinki czerwonej MCH średnia masa hemoglobiny w krwince czerwonej MCHC średnie stężenie hemoglobiny w krwince czerwonej RDW R 2021 -05 -25 miara zróżnicowania wielkości erytrocytów retykulocyty 4

Wskaźniki: płytki PLT liczba płytek krwi MPV średnia objętość płytki krwi 2021 -05 -25 5

UKŁAD CZERWONOKRWINKOWY 1. 2. 3. 4. W warunkach prawidłowych w organizmie człowieka powstaje około 2, 5 x 1011 erytrocytów na dobę Czas życia erytrocytów wynosi około 120 dni Erytrocyt jest bezjądrową komórką, kształtu dwuwklęsłej soczewki (dyskocyt) Głównym składnikiem erytrocytów jest hemoglobina 2021 -05 -25 6

HCT Ø Ø Hematokryt stanowi frakcję objętościową erytrocytów w pełnej krwi i zależy od ich ilości i objętości NORMA ♀ 37 - 47% ♂ 40 - 54% 2021 -05 -25 7

HCT (najbardziej miarodajny, pojedyńczy pomiar w ocenie niedokrwistości i nadkrwistosci) Ø Ø Nadkrwistości pierwotne Nadkrwistości wtórne Odwodnienie Spadek objętości krążącego osocza HCT Ø Ø Ø Niedokrwistości Ciąża (druga połowa)- spadek HCT związany jest ze wzrostem objętości krążącego osocza Przewodnienie 2021 -05 -25 8

RBC Ø Ø Liczba erytrocytów w 1 mm 3 krwi – obecnie ustalana jest metodami elektronicznymi lub jak dawniej w komorze Bürkera lub Thoma-Zeissa NORMA ♀ 3, 8 - 5, 0 x 1012/l ♂ 4, 2 - 5, 4 x 1012/l 2021 -05 -25 9

RBC Ø Nadkrwistości objawowe spowodowane niedotlenieniem tkanek Nadkrwistości objawowe spowodowane zwiększonym wytwarzaniem erytropoetyny Wpływ kortykosteroidów: Zespół Cushinga, leczenie steroidami Odwodnienie n RBC Ø Ø Ø Niedokrwistości Ø Nagła utrata krwi Ø Późny okres ciąży Ø 2021 -05 -25 Przewodnienie Ø 10

MCV Ø Ø Średnia objętość krwinki czerwonej: umożliwia scharakteryzowanie typu niedokrwistości NORMA 80 - 94 mm 3 normocytowa krwinka 80 -94 fl (femtolitry 10 -15) < 80 fl > 100 fl 2021 -05 -25 mikrocytowa krwinka makrocytowa krwinka 11

NIEDOKRWISTOŚĆ MIKROCYTOWA (MCV< 80 mm 3) Przyczyny niedokrwistości: Ø Niedobór żelaza Choroby przewlekłe( zakażenia, nowotwory, upośledzone wchłanianie, przewlekła utrata krwi) Talasemia (wrodzone zaburzenie syntezy Ø Niedokrwistość syderoblastyczna Ø Ø globiny) (wrodzone zaburzenie syntezy hemu) 2021 -05 -25 12

NIEDOKRWISTOŚĆ NORMOCYTOWA (MCV w normie) Przyczyny niedokrwistości: q Utrata erytrocytów q Niedostateczne wytwarzanie erytrocytów Ø 2021 -05 -25 Pierwotne uszkodzenie szpiku Ø Wtórne uszkodzenia szpiku 13

NIEDOKRWISTOŚĆ MAKROCYTOWA (MCV> 94 mm 3) Przyczyny niedokrwistości: q Niedokrwistości megaloblastyczne Ø Ø 2021 -05 -25 Na tle niedoboru witaminy B 12 Na tle niedoboru kwasu foliowego Niedokrwistości polekowe Zespół mielodysplastyczny 14

MCH Ø Ø Ø średnia masa hemoglobiny w krwince MCH powinno korelować z pozostałymi dwoma wskaźnikami Wintrobe’a (MCV i MCHC) NORMA 27 - 34 pg (pikogram 10 -12 g) 1, 7 - 2, 1 fmol (femtomol 10 -15 mol) 2021 -05 -25 15

MCH Ø Ø Ø Niedokrwistość makrocytowa Wysoki odsetek retikulocytów Marskość wątroby MCH Ø Ø Ø Niedobór żelaza Niedokrwistość mikrocytarna Nowotwory 2021 -05 -25 16

MCHC Ø Ø Ø Średnie stężenie Hb w krwince MCHC jest używany do określania barwliwości krwinek czerwonych NORMA 32 -36 g/dl 20 - 22 mmol/l 2021 -05 -25 17

MCHC Ø Ø Sferocytoza Bardzo ciężkie przedłużające się odwodnienie MCHC Ø Ø Ø Niedokrwistość mikrocytowa Przewodnienie 2021 -05 -25 18

RDW Ø Ø Ø RDW jest miarą rozkładu objętości krwinek czerwonych NORMA 11, 5 - 14, 5% Prawidłowe RDW oznacza względna homogenność komórek, natomiast RDW powyżej 15% świadczy o heterogenności (anizocytozie) krwinek czerwonych RDW razem z MCV służy do różnicowania niedokrwistości 2021 -05 -25 19

RDW (prawidłowe) Ø Ø Ø MCV < 80 mm 3 : Niedokrwistość jednorodna mikrocytowa MCV w normie: Niedokrwistość jednorodna normocytowa MCV > 94 mm 3 : Niedokrwistość makrocytowa 2021 -05 -25 20

HGB Ø Ø Hemoglobina jest białkiem znajdującym się w erytrocytach, składa się z dwóch par łańcuchów a i nie- a (b, g lub d) oraz hemu wiążącego żelazo NORMA ♀ 6, 8 - 9, 3 mmol/l 11 - 15 g/dl ♂ 7, 4 - 10, 5 mmol/l 12 - 17 g/dl 2021 -05 -25 21

HGB Ø Ø Nadkrwistości Odwodnienie HGB Ø Ø Ø Niedokrwistości Przewodnienie 2021 -05 -25 22

ERYTROPOEZA à Wielopotencjalna komórka macierzysta Mieloidalna komórka macierzysta prekursorowa komórka macierzysta dla układu czerwonokrwinkowego (BFU- E) Proerytroblast Erytroblast zasadochłonny Erytroblast obojętnochłonny Erytroblast kwasochłonny à Retykulocyt à Dojrzały erytrocyt à à à 2021 -05 -25 23

RETYKULOCYTY (Rtc) Ø Ø Liczba retykulocytów odzwierciedla aktywność eryropoetyczną szpiku kostnego NORMA 0, 3 - 1, 5% (3 - 15‰) 2021 -05 -25 24

Rtc Ø Ø Ø Niedokrwistości Okres leczenia preparatami krwiotwórczymi Po splenektomii Przerzuty nowotworowe do kości Upośledzenie produkcji erytrocytów na różnym tle 2021 -05 -25 25

RETYKULOCYT 2021 -05 -25 26

ZMIANY ERYTROCYTÓW W ZAKRESIE WIELKOŚCI 2021 -05 -25 27

MIKROCYT I NORMOCYT Mikrocyt Ø Ø Wielkość komórki < 60 mm Głównie niedokrwistości z niedoboru żelaza 1. Mikrocyty 2. Normocyty 2021 -05 -25 28

NORMOCYT I MAKROCYT Makrocyt Ø Ø Ø Wielkość komórki >9, 0 mm Niedokrwistości makrocytowe (niedobór B 12 i kw. foliowego) choroby wątroby 1. Makrocyty 2. Owalocyty 2021 -05 -25 29

MEGALOCYT Megalocyt Ø Ø Objętość komórki 150 - 160 mm 3 Niedokrwistości megaloblastyczne 1. Makrocyt 2. Mikrocyt 3. Owalocyt 4. Schistocyt 2021 -05 -25 30

ANIZOCYTOZA Ø Ø 2021 -05 -25 Jednoczesne występowanie krwinek różnej wielkości Wszystkie ciężkie niedokrwistości( szczególnie ze wzmożoną odnową) 31

ZMIANY ERYTROCYTÓW W ZAKRESIE KSZTAŁTU 2021 -05 -25 32

SFEROCYT Sferocyt Ø Ø Ø 2021 -05 -25 Krwinka kulista brak przejaśnienia, zmniejszona oporność osmotyczna Sferocytoza wrodzona (=wrodzona niedokrwistoś hemolityczna), niedokrwistości hemolityczne nabyte (immunohemolityczne), 33
OWALOCYT Owalocyt Ø =Eliptocyt, krwinka owalna, Ø Ø 2021 -05 -25 Niedokrwistości megaloblastyczne, z niedoboru żelaza, owalocytoza dziedziczna, zwłóknienie szpiku (w osteomielosklerozie), talasemia 34

DREPANOCYT Ø Ø Ø 2021 -05 -25 Krwinka sierpowata Po utracie O 2 przybiera kształt sierpa Niedokrwistość sierpowatokrwinkowa (spotykana głównie wśród ludności murzyńskiej i w basenie Morza Śródziemnego), hemoglobinopatie 35

KRWINKA TARCZOWATA Ø Ø Ø 2021 -05 -25 Płaskie krwinki wykazujące brzeżnie i centralnie zgromadzenie hemoglobiny z wolnym obszarem pomiędzy nimi, który daje obraz tarczy Hemoglobinopatie zastój żółci, talasemie, stan po splenektomii 36

AKANTOCYT Ø Ø 2021 -05 -25 Krwinka z kilkoma kolcami o różnej wielkości nierównomiernie rozmieszczonymi na powierzchni krwinki Abetalipoproteinemia (wrodzona akantocytoza), niedokrwistości hemolityczne, u chorych ze sztucznymi zastawkami serca, NNH, po splenektomii) 37

SCHISTOCYT Ø Ø Ø 2021 -05 -25 Fragmenty krwinek czerwonych, ich obecnośc dowodzi zwiększonego niszczenia (hemolizy) Hemolityczne niedokrwistości DIC, TTP, protezy naczyniowe, sztuczne zastawki, ciężkie oparzenia 38

POIKILOCYTOZA Ø Ø 2021 -05 -25 Różnokształtność krwinek Niedokrwistości makrocytowe, wzmożona erytropoeza, hemopoeza pozaszpikowa 1. Krwinka tarczowata 2. Owalocyt 3. Akantocyt 4. Stomatocyt 5. Schistocyt 6. Krwinka polichromatofilna 39

ZMIANY ERYTROCYTÓW W ZAKRESIE BARWLIWOŚCI 2021 -05 -25 40

HIPOCHROMIA Hipochromia Ø Ø Ø Niedobarwliwość na skutek zmniejszonej ilości hemoglobiny MCH 15 - 26 mg Niedokrwistość z niedoboru żelaza, a- i b- talasemia, niedokrwistość chorób przewlekłych, niedokrwistość syderoblastyczna Normochromia 2021 -05 -25 Ø MCH 27 - 34 mg 41

POLICHROMATOFILIA 1. 2. 3. 4. 5. 2021 -05 -25 6. Wielobarwliwość, wynikająca najczęściej ze zróżnicowania stopnia dojrzałości poszczególnych erytrocytów Polichromatyczne erytrocyty są wyrazem wzmożonej erytropoezy Niedokrwistość pokrwotoczna, niedokrwistości hemolityczne, przerzuty nowotworowe do szpiku, czerwienica 42

NIEPRAWIDŁOWE POSTACIE I STRUKTURY WEWNĄTRZCZERWONOKRWINKOWE 2021 -05 -25 43

CIAŁKA HOWELL- JOLLY’EGO Ø Ø Ø 2021 -05 -25 Drobne, okrągłe ziarna, o średnicy 0, 5 - 1, 0 mm będące resztkami chromatyny jądrowej , barwiącej się na kolor czerwonofioletowy Fizjologicznie występują w krwinkach noworodków Stany upośledzonej czynności śledziony, po splenektomii, niedokrwistość megaloblastyczna, zespoły mielodysplastyczne i proliferacyjne szpiku 44

PIERŚCIENIE CABOTA 1. 2. 3. 2021 -05 -25 Wewnątrzkomórkowe pierścienie lub ósemki, barwiące się metodą MGG purpurowo, będące prawdopodobnie fragmentami wrzeciona mitotycznego erytroblastów zniszczonego na skutek nieprawidłowej erytropoezy Niedokrwistości makrocytarne, zatrucia metalami ciężkimi 45

ERYROBLAST Ø Ø Ø 2021 -05 -25 Jądrowe erytrocyty w krwi obwodowej, są wynikiem intensyfikacji erytropoezy lub upośledzenia „ zapory szpikowej” Erytroleukemia, osteomielofibroza, przerzuty nowotworowe do szpiku, przełomy hemolityczne, intensywna odnowa po krwotokach 46

UKŁAD BIAŁOKRWINKOWY Ø Ø Krwinki białe są bezbarwnymi, jądrzastymi komórkami Krwinki białe produkowane są w szpiku kostnym i tkance limfatycznej Podstawową funkcją krwinek białych jest obrona ustroju przed mikroorganizmami W warunkach prawidłowych rozróżniamy 5 rodzajów krwinek białych ( leukocytów) 2021 -05 -25 47

RODZAJE KRWINEK BIAŁYCH Ø Ø Ø Granulocyty obojętnochłonne- neutrofile Granulocyty kwasochłonne- eozynofile Granulocyty zasadochłonne- bazofile Monocyty Limfocyty 2021 -05 -25 48

WBC Ø Ø Ø W celu wstępnej oceny krwinek białych oznacza się ich liczbę (WBC) NORMA 4000 - 10 000/ml 4, 0 - 10, 0 x 109/l Leukocytoza- wzrost liczby leukocyt ów powyżej normy Leukopenia- spadek liczby leukocytów Granulocytopenia (neutropenia) spadek liczby granulocytów obojętnochłonnych Agranulocytoza- brak granulocytów obojętnochłonnych 2021 -05 -25 49

WBC Ø Ø Ø Zakażenia (bakteryjne, pierwotniakowe, grzybicze, wirusowe) Stany zapalne Choroby nowotworowe Hematologiczne zespoły rozrostowe (PBSz, rzadziej ostra białaczka, czerwienica, nadpłytkowośc Uszkodzenia tkanek Wynik działania adrenaliny i hormonów sterydowych 2021 -05 -25 50

WBC Ø Ø Ø Przerzuty nowotworowe do szpiku kostnego Zakażenia: wirusowe, bakteryjne pierwotniakowe Wyniszczenie Leki (sulfamidy, niesterydowe lelki przeciw zapalne, tyreostatyki, leki przeciwpadaczkowe, doustne leki przeciwcukrzycowe, niektóre antybiotyki) 2021 -05 -25 51

WBC Ø Ø Ø Samoistna aplazja i hipoplazja szpiku kostnego Uszkodzenia szpiku kostnego przez środki chemiczne, leki, promieniowanie jonizujące Białaczki aleukemiczne Białaczka włochatokomórkowa Zespoły mielodysplastyczne Szpiczak plazmocytowy 2021 -05 -25 52

LYM Ø NORMA limfocytów 20 - 40% leukocytów 1, 5 - 3, 0 x 109/l 2021 -05 -25 53

LYM Ø Ø Ø Przewlekła białaczka limfocytowa Niektóre chłoniaki złośliwe Choroby zakaźne(mononukleoza zakaźna, krztusiec, cytomegalia, ostre zapalenie wątroby) LYM Ø Ø Ø Ø Stosowanie kortykosterydów Ciężkie zakażenia wirusowe Zaawansowana choroba nowotworowa Wtórne defekty odpornościowe Wrodzone defekty odpornościowe Niewydolność nerek i krążenia 2021 -05 -25 54

BASO Ø Ø Granulocyty zasadochłonne (bazofile) NORMA 0 -1% leukocytów 0, 00 - 0, 2 x 109/l 2021 -05 -25 55

BASO Ø Ø Przewlekła białaczka szpikowa Przewlekłe stany zapalne przewodu pokarmowego Niedoczynność tarczycy Choroba Hodgkina BASO Ø Ø Ø Ostre infekcje Ostra gorączka reumatyczna Ostre zapalenie płuc Nadczynność tarczycy Stres 2021 -05 -25 56

Eos Ø Ø Granulocyty kwasochłonne (eozynofile) NORMA 2 - 4% leukocytów 0, 00 - 0, 45 x 109/l 2021 -05 -25 57

Eos Ø Ø Ø Choroby pasożytnicze W niektórych zespołach dermatologicznych Ziarnica złośliwa, białaczka eozynofilowa W chorobach o etiologii alergicznej W przewlekłych zaburzeniach żołądkowojelitowych Eos Ø Ø Wpływ działania hormonów nadnerczowych i ACTH Odpowiedz na różnego rodzaju stresy( ostre zakażenia, urazy, zabiegi chirurgiczne, oparzenia, wysiłek fizyczny 2021 -05 -25 58

NEUT Ø Ø Granulocyty obojętnochłonne (neutrofile) NORMA 50 - 70% leukocytów 1, 5 - 7, 7 x 109/l 2021 -05 -25 59

NEUT Neutrocytoza > 8, 0 x 109/l Ø Ø Zakażenia miejscowe i uogólnione bakteryjne wirusowe, grzybicze, pierwotniakowe, pasożytnicze Choroby nowotworowe (rak oskrzela, trzustki, żołądka) Choroby hematologiczne (czerwienica prawdziwa, przewlekła białaczka szpikowa, zespoły hemolityczne) Pourazowe uszkodzenia tkanek (zawał mięśnia sercowego, oparzenia, stany pooperacyjne) 2021 -05 -25 60

NEUT Neutropenia < 1, 5 x 109/l Ø Ø Niedokrwistość aplastyczna Toksyczne uszkodzenie szpiku kostnego Leczenie cytostatykami i promieniowaniem jonizującym Zakażenia bakteryjne, wirusowe, grzybicze, pierwotniakowe 2021 -05 -25 61

MONO Ø NORMA monocytów 2 -8% leukocytów 0, 00 - 0, 8 x 109/l 2021 -05 -25 62

MONO Monocytoza > 0, 8 x 109/l Ø Ø Zakażenia bakteryjne, pierwotniakowe Mononukleoza zakaźna Reakcje zapalne (urazy chirurgiczne, kolagenozy, choroby przewodu pokarmowego) Choroby nowotworowe (białaczka monocytowa i mielomonocytowa, guzy lite) MONO Ø Ø Ø Po leczeniu glikosterydami Podczas infekcji powodujących neutropenię 2021 -05 -25 63

LUC Ø Duże peroksydazoujemne komórki: Reaktywne limfocyty Plazmocyty Erytroblasty Limfoblasty NORMA 0 - 4% leukocytów 0, 00 - 0, 25 x 109/l 2021 -05 -25 64

LUC Ø Ø Ø Choroby proliferacyjne układu chłonnego (przewlekła białaczka limfatyczna, białaczka prolimfocytowa, białaczka włochatokomórkowa, ostre białaczki limfoblastyczne, szpiczak plazmocytowy) 2021 -05 -25 65

MID Ø Ø Średnie i duże krwinki białe: Eozynofile Bazofile Monocyty Blasty, itp. NORMA 3 - 13% leukocytów 0, 3 - 1, 6 x 109/l !!!!!! 2021 -05 -25 66

UKŁAD HEMOSTAZY Ø Ø Płytki krwi są bezjądrzastymi komórkami o średnicy 2 - 4 mm Fizjologiczne zmiany liczby płytek w ciągu doby wynoszą około 10% ( u kobiet w czasie krwawienia miesięcznego liczba płytek krwi może ulec zmniejszeniu od 2550%) 2021 -05 -25 67

PLT Ø NORMA 150 - 400 x 109/l 2021 -05 -25 68

PLT Ø Ø Ø Zespoły mieloproliferacyjne Reakcje fazy ostrej Przewlekłe choroby zapalne (reumatoidalne zapalenie stawów, gorączka reumatyczna, marskość wątroby) Choroby nowotworowe (rak, ziarnica złośliwa, chłoniaki) Krwawienia i stany niedoboru żelaza Kortykosteroidy 2021 -05 -25 69

PLT q Małopłytkowość spowodowana zmniejszonym lub upośledzonym wytwarzaniem płytek Ø Wrodzone Ø Nabyte Małopłytkowość spowodowana zwiększonym niszczeniem płytek Ø Infekcje Ø Leki Ø Infekcja HIV q 2021 -05 -25 70

PLT q q Małopłytkowość spowodowana sekwestracją płytek Małopłytkowość spowodowana utratą płytek Krwawienia Krążenie pozaustrojowe Ø Hemodializa Ø Ø 2021 -05 -25 71

MPV Ø Średnia objętośc płytek Ø NORMA 7, 8 - 12, 0 fl 2021 -05 -25 72

MPV Ø Ø Obecność płytek olbrzymich Odnowa układu płytkotwórczego 2021 -05 -25 73

DZIĘKUJĘ ZA UWAGĘ 2021 -05 -25 74
- Slides: 74